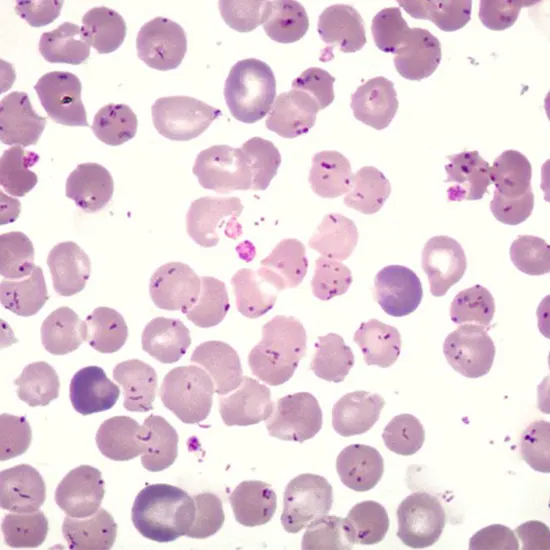
Carrion's Disease

Book Carrion's Disease Appointment Online Near me at the best price in Delhi/NCR from Ganesh Diagnostic. NABL & NABH Accredited Diagnostic centre and Pathology lab in Delhi offering a wide range of Radiology & Pathology tests. Get Free Ambulance & Free Home Sample collection. 24X7 Hour Open. Call Now at 011-47-444-444 to Book your Carrion's Disease at 50% Discount.
Carrion's disease, also known as Oroya fever or Bartonellosis, is a bacterial infection caused by the bacterium Bartonella bacilliformis. It is primarily found in South America. it passes on to human being through the bite of infected sandflies. The symptoms of Carrion’s Disease includes abdominal pain, fatigue, headache, low grade fever, poor digestive system, An enlarged liver, enlarged Spleen etc.
The diagnosis of Carrion's disease is typically based on clinical presentation, history of exposure in an endemic area, and laboratory tests such as blood smears, serological tests, and molecular tests to detect the presence of Bartonella bacilliformis DNA.
Our Carrion’s Disease Test Package Includes:
|
Giemsa Stain |
|
175 |
|
Blood Culture and Sensitivity |
|
250 |
|
Complete Hemogram |
|
225 |
|
CECT Abdomen |
|
4200 |
|
Total Price |
|
4850 |
| Test Type | Carrion's Disease |
| Includes | Carrion's Disease (Common Diseases) |
| Preparation | |
| Reporting | Within 24 hours* |
| Test Price |
₹ 4850
|

Early check ups are always better than delayed ones. Safety, precaution & care is depicted from the several health checkups. Here, we present simple & comprehensive health packages for any kind of testing to ensure the early prescribed treatment to safeguard your health.